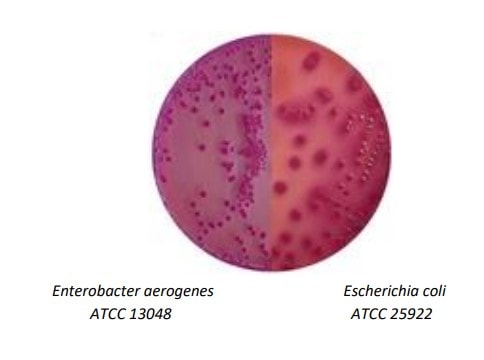
agar macckonkey modo de uso

SKU: K25-1052
R$ 467,47 no Pix
ou R$ 481,93 em até em até 9x de R$ 53,55 sem juros no cartão
Formas de pagamento
| 1x de R$ 467,47 sem juros | R$ 481,93 |
| 1x de R$ 467,47 sem juros | R$ 481,93 |
| 1x de R$ 481,93 sem juros | R$ 481,93 |
| 2x de R$ 240,96 sem juros | R$ 481,93 |
| 3x de R$ 160,64 sem juros | R$ 481,93 |
| 4x de R$ 120,48 sem juros | R$ 481,93 |
| 5x de R$ 96,39 sem juros | R$ 481,93 |
| 6x de R$ 80,32 sem juros | R$ 481,93 |
| 7x de R$ 68,85 sem juros | R$ 481,93 |
| 8x de R$ 60,24 sem juros | R$ 481,93 |
| 9x de R$ 53,55 sem juros | R$ 481,93 |
Qtd:
Calcular o valor do frete e prazo de entrega
Entrega segura
receba seu pedido com total segurança e tranquilidade
Confiança
Há mais de 40 anos no mercado
Entrega
em todo o Brasil.
O Agar MacConkey é um meio de cultura utilizado para o isolamento e identificação de enterobactérias a partir de amostras de fezes, urina, água residual e alimentos, conforme descrito na Farmacopeia Europeia, USP e ISO 21567.
Utilizado para o isolamento seletivo de enterobactérias, especialmente gram-negativas, em amostras clínicas e ambientais. Pode ser usado após enriquecimento em caldos seletivos como Tetrationato, Selenito Cistina, GN ou MacConkey.
O crescimento de colônias pode indicar a presença de Escherichia coli. A confirmação deve ser feita por testes adicionais. Colônias de E. coli são vermelhas/rosas com precipitação de bile ao redor.
| Microorganismo | Características |
|---|---|
| Escherichia coli | Colônias vermelhas ou rosas, não mucoides, com precipitado opaco |
| Klebsiella | Colônias vermelhas, mucoides e largas |
| Enterobacter aerogenes | Colônias vermelhas a rosas |
| Serratia | Colônias vermelhas a rosas, não mucoides |
| Arizona e Citrobacter | Colônias transparentes ou vermelhas (se fermentam lactose) |
| Salmonella | Colônias sem coloração, transparentes ou âmbar |
| Shigella | Colônias sem coloração ou levemente rosas |
Os testes foram realizados a 35 ± 2°C por 24 horas. A taxa de recuperação foi ≥ 30% para culturas padrão como E. coli, Proteus vulgaris, Salmonella enteritidis, e Shigella dysenteriae. Staphylococcus aureus foi inibido.
Manter o meio desidratado bem fechado para evitar hidratação. Proteger contra umidade e luz. Respeitar os limites de temperatura recomendados.
R$ 101,83 no Pix
ou R$ 104,98 em até em até 2x de R$ 52,49 sem juros no cartão
R$ 431,27 no Pix
ou R$ 444,61 em até em até 8x de R$ 55,58 sem juros no cartão
R$ 506,34 no Pix
ou R$ 522,00 em até em até 10x de R$ 52,20 sem juros no cartão
R$ 509,25 no Pix
ou R$ 525,00 em até em até 10x de R$ 52,50 sem juros no cartão
R$ 509,25 no Pix
ou R$ 525,00 em até em até 10x de R$ 52,50 sem juros no cartão
Utilizamos cookies para personalizar anúncios e melhorar a sua experiência no site. Ao continuar navegando, você concorda com a nossa Política de Privacidade.